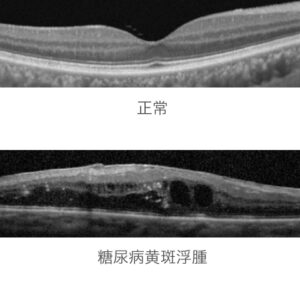
糖尿病網膜症について

-
切らない霰粒腫治療IPL
こんにちは!IPL担当看護師です。今回は『切らない霰粒腫治療IPL』について説明します。 ★霰粒腫とは瞼にある涙の表面に油を分泌するマイボーム腺の出口が詰まり、中に分泌物が溜まってしまうことで肉芽種と呼ばれる塊ができた状 […]
2026.04.11
-
4月の診療カレンダー
4月の診療カレンダーです。 よろしくお願いいたします。
2026.03.23
-
飛蚊症について
こんにちは。受付の加藤です。 🌤少しずつ日差しが柔らかくなってきて、 朝の散歩も心地よく感じられるようになりました、皆様お変わりございませんでしょうか🌸 皆さんは、日常で黒い点や線などが見えることはございませんか? 本日 […]
2026.03.02
-
3月の診療カレンダー
3月の診療カレンダーです。 よろしくお願いいたします。
2026.02.24
-
2月の診療カレンダー
2月の診療カレンダーです🍫💝 よろしくお願いいたします。
2026.01.26
-
リジュセアミニ点眼液0.025%処方開始いたしました
こんにちは院長の新海です。 これまで当院ではお子様の近視進行抑制治療の一つとしてマイオピンの点眼薬(0.01%と0.025%)を処方してまいりましたがリジュセアミニ点眼液0.025%の取り扱いを開始いたしました。現在マイ […]
2026.01.22
-
グラジェノックスについて
こんにちは🐎 受付の大川です🏇本年もよろしくお願いいたします🐴✨ 今回は【グラジェノックス】というサプリメントについてご紹介します! 📛グラジェノックスとは? 抗酸化作用や、血流や血管に対する […]
2026.01.19
-
年末年始のお休みと1月の診療カレンダー
年末年始のお休みは12/28(日)~1/4(日)までです。 1/5(月)から通常通りの診療となります。 よろしくお願いいたします。
2025.12.22
-
糖尿病網膜症について
こんにちは!検査員の坂下です⛄ 今年も残すことあとわずかになりましたね。 寒さも厳しくなってきたので、体調管理をしっかりしていきたいですね✨ 今日は『糖尿病網膜症』について書いていきたいと思います。 糖尿病 […]
2025.12.15
-
新しい多焦点眼内レンズ TECNIS PureSee 導入
こんにちは院長の新海です。この度当院でJohnson&Johnson製の最新の多焦点眼内レンズTECNIS PureSeeを導入いたしました! PureSeeは従来の多焦点レンズと比較してハロー・グレア等の夜間光 […]
2025.12.09